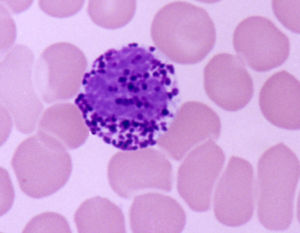
嗜鹼性粒細胞 嗜鹼性粒細胞

簡介

形態特點
嗜鹼性粒細胞細胞來源
嗜鹼性粒細胞起源於骨髓造血多能幹細胞,在骨髓內分化成熟後進入血流。肥大細胞的來源尚有爭議,人類肥大細胞的起源以及肥大細胞與嗜鹼性粒細胞之間的關係仍不清楚。已確知α鼠肥大細胞來自骨髓的造血多能幹細胞,在各種組織的微環境內成熟,形成結締組織肥大細胞和黏膜肥大細胞。結締組織肥大細胞體積較大,胞質顆粒多,組胺含量高,對藥物比較敏感。
參考值
正常參考值
百分值0~0.01或(0%—1%)
絕對值0~0.110^9/L
異常分析
嗜鹼性粒細胞嗜鹼性粒細胞白血病(罕見)、慢性粒細胞性白血病常伴有嗜鹼性粒細胞增高,骨髓纖維化症、慢性溶血及脾切除後也可見嗜鹼性粒細胞增高。
嗜鹼性粒細胞減少:
①Ⅰ型超敏反應(速髮型變態反應),如蕁麻疹、過敏性休克等;促腎上腺皮質激素及糖皮質激素過量;甲亢;庫欣症等;
②應激反應,如心梗、嚴重感染、出血等。
臨床意義
嗜鹼性粒細胞1)過敏性或炎症性疾病:如蕁麻疹、潰瘍性結腸炎。蕁麻疹因過敏體質對特異抗原過敏或物理因素(寒冷等)引發,血清IgE增高,寒冷性蕁麻疹患者血清中還可出現冷球蛋白或冷纖維蛋白原等。潰瘍性結腸炎可見RBC減低、缺鐵性貧血、急性期WBC、中性粒細胞、嗜酸性粒細胞增多。
2)骨髓增生性疾病:如真性紅細胞增多症、原發性骨髓纖維化、慢性粒細胞性白血病。嗜鹼性粒細胞持續>0.1×109/L,是骨髓增生性疾病的共同特徵。真性紅細胞增多症,嗜鹼性粒細胞輕度增高(1×109/L)。原發性纖維化,貧血、出現幼稚紅細胞、幼稚粒細胞、WBC增高、以中性粒細胞為主、嗜鹼性粒細胞、嗜酸性粒細胞輕度增多。慢性粒細胞性白血病,輕度貧血、WBC增多、嗜酸性粒細胞、嗜鹼性粒細胞增多,達2%~3%,高達20%~90%者提示預後不良。
3)嗜鹼性粒細胞白血病:罕見類型白血病,嗜鹼性粒細胞異常增多,達20%以上,且多幼稚型。(2)減少:見於甲狀腺功能亢進、妊娠、放療、化療、糖皮質激素治療、感染急性期。
免疫系統
| 系統 | 自適應與天然 | 體液與細胞 | 補體(過敏毒素) | 固有 |
| 抗原與抗體 | 抗原 (超抗原;變應原) | 半抗原 |
| 表位 (線性;構象) | |
| 抗體 (單克隆抗體; 多克隆抗體;自身抗體) | 多克隆B細胞反應 | 同種異型 | 同種型 | 遺傳型 | |
| 免疫複合物 | |
| 免疫細胞/白細胞 | 淋巴系細胞: T細胞 | B細胞 | NK細胞 |
| 髓系細胞:肥大細胞 | 嗜鹼性粒細胞 | 嗜酸性粒細胞 | 巨噬細胞 | |
| 吞噬細胞:中性粒細胞 | 巨噬細胞/網狀內皮系統 | |
| 專職型 APCs:樹突狀細胞 | 巨噬細胞 | B細胞 | |
| 免疫與耐受 | 作用:免疫性 | 自身免疫 | 變態反應 | 炎症 | 交叉反應性 |
| 無作用:耐受 (中樞耐受;外周耐受;克隆無能;克隆缺失) | 免疫缺損 | |
| 免疫遺傳學 | 體細胞超突變 | V(D)J 重組 | 免疫球蛋白類別轉換 | MHC/HLA |
| 免疫物質 | 細胞因子 | 調理素 | 溶細胞素 |
| 其他 | 診斷免疫學 |
免疫系統/ 免疫學
| 免疫系統 | 它是人體抵禦病原菌侵犯最重要的保衛系統。 |
| 系統 | |
| 抗原與抗體 | 抗原 (超抗原, 變應原) | 半抗原 表位 (線性表位, 構象表位) 抗體 (單克隆抗體, 多克隆抗體, 自身抗體) | 多克隆B細胞反應 | 同種異型 | 免疫球蛋白同種異型 | 遺傳型 | 免疫複合物 |
| 免疫細胞/白細胞 | 淋巴系細胞:T細胞 | B細胞 | NK細胞 髓系細胞:肥大細胞 | 嗜鹼性粒細胞 | 嗜酸性粒細胞 | 巨噬細胞 吞噬細胞:中性粒細胞 | 巨噬細胞 | 網狀內皮系統 抗原遞呈細胞:樹突狀細胞 | 巨噬細胞 | B細胞 |
| 免疫 與 耐受 | 作用:免疫性 | 自身免疫 | 變態反應 | 炎症 | 交叉反應性 無作用:耐受 (中樞耐受, 外周耐受, 克隆無能, 克隆缺失) | 免疫缺損 |
| 免疫遺傳學 | 體細胞超突變 | V(D)J 重組 | 免疫球蛋白類別轉換 | MHC/HLA |
| 免疫物質 | 細胞因子 | 調理素 | 溶細胞素 |
| 其他 | 診斷免疫學 |